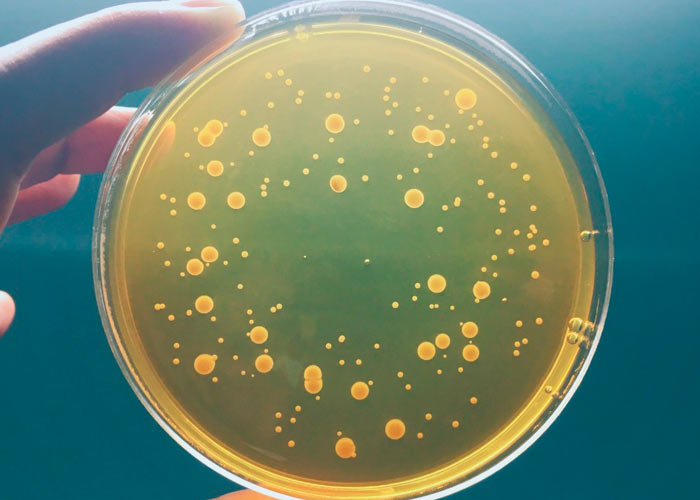
Направления микробиологии Направления микробиологии

Содержание
- Введение в микробиологию: термины, понятия и структура
- О микроорганизмах и их важности
- Направления микробиологии
- Бактериология: размножение, среда, питание
- О фазах размножения
- Питательная среда и требования к ней
- Основные источники питания
- Классификация питательной среды
- Культивирование бактерий
Введение в микробиологию: термины, понятия и структура

Наука под названием микробиология полностью посвящена изучению микроскопических живых организмов, которые принято именовать в упрощенной версии микроорганизмами. Естественно, данная область знаний охватывает не только биологические признаки существ, но и систематизирует их, исследует экологию и взаимодействие с окружающей средой, включая флору и фауну.
О микроорганизмах и их важности
Что принято считать микроорганизмами:
- бактерии;
- актиномицеты;
- грибы;
- дрожжи;
- а также вирусы, фаги и т.д.
На практике, микроорганизмам в природе отводится крайне важная роль. Ведь именно благодаря им выполняется непрерывное движение неорганических и органических соединений. Например, обязательных: серы, азота, фосфора и пр. Помимо этого, микроскопические организмы осуществляют непосредственную минерализацию остатков животного и растительного происхождения. Однако есть и обратная негативная сторона. «Герои» статьи своей активностью способны наносить колоссальный ущерб сырьевым материалам, продуктам питания, органике. Нередко они образуют чрезвычайно вредные, токсичные вещества, а также становятся ключевыми возбудителями всевозможных заболеваний у людей, животных и растений.
Человек смог найти широкое применение микроорганизмов в пищевой, легкой и химической промышленности, медицине и т.д. Производство вина, закваска овощей и фруктов, варка пива, изготовление хлебобулочных изделий, кисломолочных продуктов – лишь небольшой спектр в пищепроме. А ведь еще есть антибиотики, витамины, органические кислоты, спирты, ферменты и многое другое!
Направления микробиологии
Прямо сейчас общепринятыми самостоятельными ветками данной науки считаются:
Медицинская микробиология – посвящена патогенным микроорганизмам, способным вызывать в организме человека различные заболевания; кроме исследований, ученые занимаются поиском и формированием новых методов диагностики, профилактических действий, а также лечения. В этот же кластер входит вирусология, однако она считается уже самостоятельным ответвлением.
Ветеринарная микробиология – задачи аналогичны предыдущему направлению, однако относительно животных.
Почвенная микробиология – микроорганизмы в контексте почвы и растений (создание питательной среды, обеспечение полезными веществами представителей флоры и т.д.).
Водная микробиология – участие в пищевых цепочках микроорганизмов, круговорот веществ, отчистка и загрязнение воды (сточной, питьевой), общая микрофлора любого водоема.
Биотехнология – дисциплина, сосредоточенная на изучении уникальных условий в развитии микроорганизмов, которые задействуют в получении препаратов и веществ, широко используемых в медицинской отрасли и промышленности. Это направление занимается разработкой научных методов биосинтеза всего доступного спектра соединений:
- ферменты;
- витамины;
- антибиотики;
- аминокислоты и пр.
Естественно, помимо разработки новых методик, прогресс позволяет совершенствовать уже существующие, рабочие методы. Также к биотехнологии относится функция выработки ряда мер по сохранению пищевых продуктов, органики и просто сырья от потенциального вреда, наносимого микроорганизмами. Четкое понимание происходящих в течение времени процессов (хранение, переработка), позволяет не только экономить финансы, но и улучшать качество любого продукта.
Генетика микроорганизмов – из всех выше перечисленных, безусловно, наиболее перспективная и молодая дисциплина, заточенная на детализированное исследование молекулярных основ наследственности, а также подверженности изменениям микроорганизмов. Эта область также отвечает за отслеживание закономерностей в процессах мутагенеза (естественного и искусственного), формирование новых методов и особенностей регуляции жизнедеятельности микроорганизмов, определение четких закономерностей процессов мутации, а также выведение новых штаммов для дальнейшего практического применения во всех доступных областях жизнедеятельности человека.
Бактериология: размножение, среда, питание

О фазах размножения
Вполне очевидно, что, обнаруживая новый бактериальный штамм, исследователи не просто его фиксируют, а приступают к последовательному изучению, основу которого составляет непосредственное размножение. Принято выделять четыре ключевых фазы:
1. Исходная стационарная (лаг-фаза) включает в себя временной промежуток активного синтеза белков, фактически, этап подготовки к быстрому росту. В зависимости от качества предоставляемой питательной среды, может длиться от двух до пяти часов.
2. Логарифмическая (лог-фаза) подразумевает максимально динамичное деление клеток. Как и предыдущий этап, длительность и скорость процессов зависят от особенностей питательной среды и выбранного бактериального штамма. Продолжительность лог-фазы занимает от считанных минут до нескольких часов.
3. Стационарная характеризуется прерыванием процесса деления клеток, их число остается неизменным. Причина очевидна – острая нехватка питательных веществ в выбранной среде и, как следствие, снижение скорости метаболизма, начало расщепления клетками белков, не являющихся жизненно необходимыми. Количество часов, относящихся к данной фазе, также определяется типом бактерий.
4. Фаза смерти говорит сама за себя. Это заключительный этап жизни микроорганизмов. Источники питания окончательно исчерпываются и бактерии отмирают. Дополнительными «стимулами» выступают: накопление кислых продуктов обмена либо так называемое самопереваривание (аутолиз), под воздействием своих же гидролитических ферментов.
Питательная среда и требования к ней

Безусловно, именно эта деталь лежит во главе угла для любых проектов, реализуемых в контексте бактериологии. Как правило, чем выше качество питательной среды, тем эффективнее результат грядущего исследования.
Перечень ключевых требований:
- Содержат максимальный спектр веществ, в которых нуждаются микробы для полноценного питания.
- Обладают необходимым уровнем влажности.
- Должный уровень кислотности pH (7,2-7,6).
- Демонстрация оптимальной изотоничности (концентрация NaCl 0,87%). В случае с галофильными бактериями этот показатель должен быть выше 1 процента.
- Наличие подходящего окислительно-восстановительного потенциала (измеряется в RH2), фиксирующего содержание кислорода в выбранной среде. Анаэробы активны в средах с RH2>10, анаэробы при RH2<5.
- Прозрачность используемой среды (для возможности наблюдать развитие микробов). Особенно актуально для жидкостей.
- Стерильность (полное отсутствие других микроорганизмов, способных оказывать стороннее влияние).
Основные источники питания
Все используемое сырье для подготовки питательной среды можно разделить на две основных группы по происхождению: синтетические и натуральные. Причем вторая категория подразделяется еще на две: животного (мясные, молочные продукты, яйца, рыба, сгустки крови, костная мука) и растительного (картофель, агар и пр.) происхождения. С синтетикой и так все понятно, речь идет о химических соединениях, как основе.
Каждый необходимый компонент питания микробов концентрирован в определенных веществах. К примеру, азот (N), бактерии получают из аминокислот, пептонов или различных аммонийных соединений. Углерод (С) – потребляя сахары, кислоты органического происхождения, полиспирты. Неорганические элементы микробы получают из вносимых солей (хлорид натрия, фосфат калия и т.д.).
Классификация питательной среды

Существует масса способов категоризации питательных сред, однако наиболее понятными и важными считаются три варианта: по типу консистенции, составу и назначению. Рассмотрим подробнее все три.
О плотности
Логично, что выделяют три группы:
- жидкие;
- полужидкие;
- твердые.
Наиболее простой способ изменения консистенции состоит в добавлении агара (продукта переработки красных водорослей), плавящегося при нагревании до 100 градусов Цельсия и остывающего на отметке в 45-50 градусов. Концентрация агара для полужидких сред не превышает 0,5% от общего объема, а плотных – не ниже 1,5%. Закономерно, что источник желатина не входит в состав жидких питательных сред.
Простые и сложные
Да, говоря о составе, мы автоматически делим выбранные среды всего на два типа. Разделять крайне легко. Вот перечень простых:
- пептонная вода;
- мясопептонный бульон;
- пептонный желатин и т.д.
Сложные среды отличаются от предыдущих лишь добавлением в них источников аминокислот, витаминов, микроэлементов и других необходимых веществ. Самые очевидные примеры – желчный либо сахарный бульон, солевой агар и пр.
Цели и предназначение
Последняя классификация наиболее запутанная, однако, попробуем разобраться. Среды снова делятся на две категории: общего назначения и специального. Грубо говоря, первые подразумевают максимальную универсальность. Они идеально подходят для первых экспериментов с новым штаммом, а также оценки общей картины для большинства микробов. Например, это может быть кровяной агар.
Среды специального назначения бывают:
- Элективными (предназначены для роста конкретных микроорганизмов, имеют узкое применение).
- Обогащения (стимулирующие активный рост выбранных микробов, угнетая любые другие).
- Дифференциально-диагностические (предназначены для исследования активности ферментов микроорганизмов).
- Комбинированные (сочетают в себе две предыдущих).
Дополнительно эксперты выделяют транспортные и селективные питательные среды, однако это уже излишнее углубление в предмет изучения.
Культивирование бактерий

Мы уже говорили в самом начале, что питательная среда является ключевым вопросом в работе бактериолога. Чем выше ее качество, тем качественнее работа будет выполнена. Именно поэтому сегодня отрасль медпрома, отвечающая за производство консервированных сред развивается семимильными шагами. Не составит труда приобрести сухую питательную среду в удобных пластиковых контейнерах, с абсолютной герметичностью и длительным сроком хранения.
Правила культивации
Готовы записывать? Тогда начнем:
- Обеспечение всех необходимых компонентов питательной среды.
- Лучший температурный режим (в основном это 37 градусов по Цельсию).
- Создание оптимального микроклимата (атмосфера). Строгим аэробам требуется кислород, а значит чашка Петри или верхний тонкий слой жидкости будут идеальным выбором. Размещение в глубинном слое жидкой среды потребует непрерывного перемешивания (либо встряхивания) для распределения оксигена равномерно. Важно! Аналогичная методика актуальна и для факультативных анаэробов. Микроаэрофилам требуется пониженное парциальное давление кислорода. При этом плотность углекислого газа должна колебаться от одного до пяти процентов. Как правило, для регуляции и контроля применяют специальные СО2-инкубаторы либо микробы размещают в эксикаторах. Облигатные анаэробы «боятся» кислорода, потому его следует исключить априори, любым из доступных способов.
- Контроль времени культивирования (в среднем от 18 до 48 часов; исключение – палочки Коха, которым требуется 21-28 суток).
- Наличие света. Яркость освещения ли его полное отсутствие – важное условие успешного роста. Фототрофные микробы нуждаются в свете.
- Выращивание облигатных внутриклеточных паразитирующих микроорганизмов выполняют непосредственно на культурах клеток либо прямо в живых организмах и эмбрионах.
Если в частном порядке реализовать культивирование бактерий, без уже существующей «дорожной карты» весьма сложно, для промышленных масштабов получение биомассы бактерий, грибов упрощается. С целью разработки вакцин, всевозможных препаратов и антибиотиков, применяются специальные аппараты-ферментеры, где гораздо легче соблюдать строгие условия оптимального развития и размножения микробов.





Будьте первым!